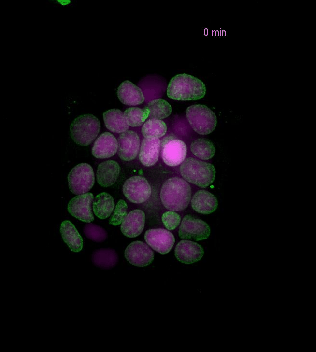
deconvolved histone and wf EGFP

Control of genomic mosaicism
How genome integrity is monitored across generations of different cellular lineages, and why the rate and distribution of genomic mosaicism vary through development, homeostasis and aging, remain open questions. We have identified that mammalian patterning signals have a moonlighting role in the regulation of genome and chromosomal stability during mammalian lineage specification. We pursue interdisciplinary projects to understand how genomic & chromosomal mosaicism arises in peri-implantation embryos: the leading cause of miscarriage in humans; as well as to characterised how microenvironmental signals contribute to the genomic resilience of different tissues, from embryonic development to ageing and disease.
Related publications: De Jaime, Hattemer et al., Nature communications 2024

Bi-directional relationship between fate and chromosomal stability
Using single cell genome and transcriptome sequencing (scG&T-seq), as well as replication sequencing (sc-EdU-seq) we monitor the bi-directional relationship between celular identity and genome stability across different human and mouse celular lineages.
Related publications: De Jaime, Hattemer et al., Nature communications 2024; Berg et al., Nature Methods 2024; De Jaime-Soguero et al., BioRxiv 2025; Haas et al., Life Science Alliance 2025.

A, pipeline one scG&T-seq. B, example of cDNA sequencing of mESCs. C, example of two different cells from (B) showing a normal karyotype (pluripotent, red) and aneuploidy (treated, grey)

Assignment of replicating forks in single cell genomes in human pluripotent stem cells using scEdU-seq. Inhibition of basal WNT activity using DKK1 during stem cell renewal increases the number of forks in each chromosome which is a feature of replicative stress.
Cell signalling & mitosis
During the complex voyage of building tissues, cells integrate intrinsic factors, as well as extrinsic cues from their niches to modulate the progression, symmetry, orientation, and fate of their divisions. Misregulation of these processes is associated with loss of the cellular hierarchies, genome instability, and can ultimately lead to disease, notably cancer. We aim to unravel how different signalling pathways, including Wnt, shape the cell fate during mammalian development and tissue renewal by modulating cell division.
Related publications: Habib & Acebrón TCB 2022, Bufe et al, PNAS 2021
Innate inmune response
 The cGAS-STING signalling pathway acts as gatekeeper in the innate immune response towards extrinsic and intrinsic sources of cytoplasmic double stranded DNA (dsDNA). Despite its relevance to monitor viral and bacterial infections, cell death, and genome instability, the lack of specific live reporters has precluded spatio-temporal analyses of cGAS-STING signalling. We created a novel cGAMP biosensor that allows for the spatio-temporal characterisation of the innate inmune response towards cytoplasmic DNA in a spate-temporal manner. Using this biosensor, we aim at determining how cells sense foreign and intrinsic DNA, as well as how these signals spread through complex 3D tissues
The cGAS-STING signalling pathway acts as gatekeeper in the innate immune response towards extrinsic and intrinsic sources of cytoplasmic double stranded DNA (dsDNA). Despite its relevance to monitor viral and bacterial infections, cell death, and genome instability, the lack of specific live reporters has precluded spatio-temporal analyses of cGAS-STING signalling. We created a novel cGAMP biosensor that allows for the spatio-temporal characterisation of the innate inmune response towards cytoplasmic DNA in a spate-temporal manner. Using this biosensor, we aim at determining how cells sense foreign and intrinsic DNA, as well as how these signals spread through complex 3D tissues
Related publications: Smarduch et al., The EMBO Journal 2025.
Wnt signalling in stem cell & cancer biology
The fate of adult stem cells is determined by the integration of extracellular signals released from their niches. For example, Wnt and R-spondin ligands are essential for stem cell maintenance and tissue homeostasis across many organs. We study the transduction of Wnt signals, notably in mammalian adult stem cells of the gut. We aim to identify and characterise signalling components, interactions and modifications that play key roles in stem cell renewal, and whose misregulation can lead to cancer.
See also Giebel, De Jaime et al., EMBO Reports 2021. Ho et al., Neuro-oncology 2024.
Wnt signal transduction & crosstalk

The extracellular signalling pathways are notorious for their cross talk, but it is still not well understood how stem and progenitor cells integrate different extracellular signals from a multi-signalling niche to modulate their fate and behaviour. We aim to characterise the fundamental molecular hubs and switches where different signalling pathways converge, and uncover biological functions regulated by these mechanisms.
See also Giebel, De Jaime et al., EMBO Reports 2021. Yuan et al., Plos Biology 2025, Fatti et al., Science Signalling 2023. De Jaime, Hattemer et al., Nature communications 2024
Collaborations
Prof. Holger Bastians – University Medical Center Göttingen (UMG)
Prof. Rocio Sotillo – DKFZ
Prof. Karl Willert – UCSD
Dr. Xabier Contreras – University of the Basque Country
Prof. Gislene Pereira – Heidelberg University
Dr. Annarita Patrizi – DKFZ
Dr. Jens Puschhof – DKFZ
Prof Anna Jausch – Heidelberg University Hospital
Dr. Johannes Betge – DKFZ
Dr. Marco Binder – DKFZ
Dr. Josephine Bageritz – Heidelberg University
Prof. Andrei Chabes –Umeå University
Dr. Vladimir Venes – EMBL
Dr. Ulrike Engel, Heidelberg University
Prof. Alexander v. Oudenaarden, Hubrecht Institute, Utrecht
Dr. Marta Shabahzi, Cambridge University
Prof. Magda Zernicka-Götz, Cambridge University

